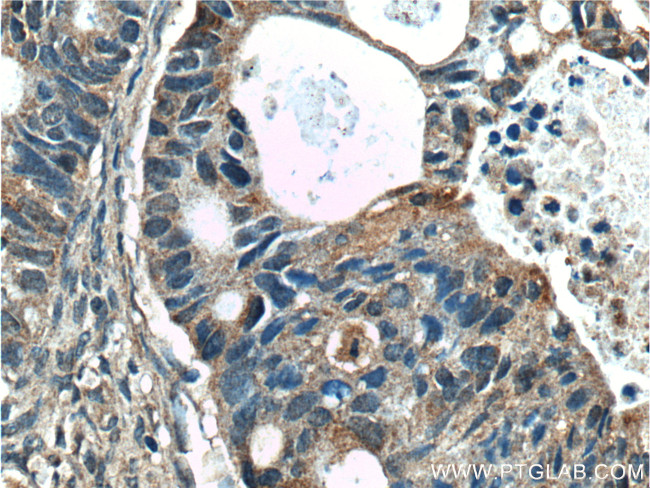
SGK2 Antibody in Immunohistochemistry (Paraffin) (IHC (P))

Search
Proteintech
SGK2 Polyclonal Antibody
{{$productOrderCtrl.translations['antibody.pdp.commerceCard.promotion.promotions']}}
{{$productOrderCtrl.translations['antibody.pdp.commerceCard.promotion.viewpromo']}}
{{$productOrderCtrl.translations['antibody.pdp.commerceCard.promotion.promocode']}}: {{promo.promoCode}} {{promo.promoTitle}} {{promo.promoDescription}}. {{$productOrderCtrl.translations['antibody.pdp.commerceCard.promotion.learnmore']}}
产品信息
11185-1-AP
种属反应
宿主/亚型
分类
类型
抗原
偶联物
形式
浓度
规格
纯化类型
保存液
内含物
保存条件
运输条件
产品详细信息
Immunogen sequence: EEGRAVHGA APQDLSRNLE FSELPDHCYR MNSSPAGTPS PQPSRANGNI NLGPSANPNA QPTDFDFLKV IGKGNYGKVL LAKRKSDGAF YAVKVLQKKS ILKKKEQSHI MAERSVLLKN VRHPFLVGLR YSFQTPEKLY FVLDYVNGGE LFFHLQRERR FLEPRARFYA AEVASAIGYL HSLNIIYRDL KPENILLDCQ GHVVLTDFGL CKEGVEPEDT TSTFCGTPEY LAPEVLRKEP YDRAVDWWCL GAVLYEMLHG LPPFYSQDVS QMYENILHQP LQIPGGRTVA ACDLLQSLLH KDQRQRLGSK ADFLEIKNHV FFSPINWDDL YHKRLTPPFN PNVTGPADLK HFDPEFTQEA VSKSIGCTPD TVASSSGASS AFLGFSYAPE DDDILDC (1-397 aa encoded by BC014037)
靶标信息
SGK2 is a serine/threonine protein kinase which is similar to serum- and glucocorticoid-induced protein kinase (SGK). Unlike SGK, SGK2 is not induced by serum or glucocorticoids. It is induced in response to signals that activate phosphatidylinositol 3-kinase, which is also true for SGK. Although little is known about the transcriptional regulation of SGK2, the protein has been shown to be phosphorylated and activated by 3 phosphoinositide dependent protein kinase 1 (PDK1), and to a lesser extent insulin like growth factor 1, in vitro.
仅用于科研。不用于诊断过程。未经明确授权不得转售。
生物信息学
蛋白别名: Serine/threonine-protein kinase Sgk2; Serum/glucocorticoid-regulated kinase 2; SGK2, serine/threonine kinase 2; unnamed protein product
基因别名: AI098171; AW146006; dJ138B7.2; H-SGK2; SGK2; Sgkl
UniProt ID: (Human) Q9HBY8, (Rat) Q8R4U9, (Mouse) Q9QZS5
Entrez Gene ID: (Human) 10110, (Rat) 171497, (Mouse) 27219